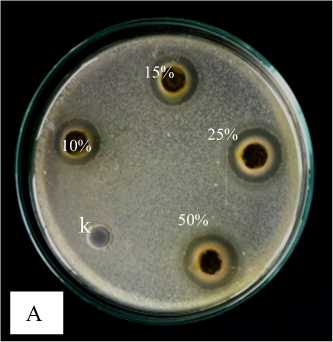
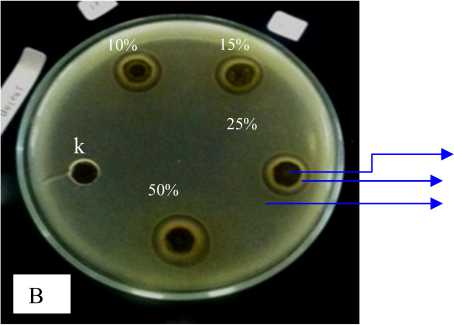

UJI FITOKIMIA DAN DAYA HAMBAT EKSTRAK DAUN JUWET (Syzygium cumini) TERHADAP PERTUMBUHAN Escherichia coli DAN Staphylococcus aureus ATCC
on
JURNAL SIMBIOSIS V (2 ): 47 - 51
Jurusan Biologi FMIPA Universitas Udayana http://ojs.unud.ac.id/index.php/simbiosis
ISSN: 2337-7224
September 2017
Directoryof OPEN ACCESS JOURNALS
UJI FITOKIMIA DAN DAYA HAMBAT EKSTRAK DAUN JUWET (Syzygium cumini) TERHADAP PERTUMBUHAN Escherichia coli DAN Staphylococcus aureus ATCC
PHYTOCHEMICAL AND INHIBITION OF JUWET LEAF EXTRACT (Syzygium cumini) ON GROWTH Escherichia coli AND Staphylococcus aureus ATCC
Kadek Sudarmi, Ida Bagus Gede Darmayasa, I Ketut Muksin
Prodi Biologi FMIPA Universitas Udayana
Bukit Jimbaran Bali
Email : sudarmikadek56@yahoo.com
INTISARI
Bakteri Escherichia coli dan Staphylococcus aureus ATCC adalah flora normal yang secara alamiah ada pada manusia. Bakteri ini dapat berubah menjadi patogen jika jumlahnya melebihi batas normal.Untuk mencegah penyakit yang ditimbulkannya, perlu diatasi dengan menggunakan bahan herbal, salah satunya adalah tumbuhan juwet (Syzygium cumini). Tujuan penelitian ini adalah untuk mengetahui apakah ekstrak daun juwet mampu menghambat pertumbuhan E. coli dan S. aureus ATCC, mengetahui pada konsentrasi berapa ekstrak daun juwet efektif menghambat pertumbuhan E. coli dan S. aureus ATCC, sera mengetahui golongan senyawa yang terkandung pada ekstrak daun juwet (S. cumini). Penelitian ini menggunakan metode sumur difusi dengan 6 perlakuan dan 4 ulangan. Analisis data menggunakan Rancangan Acak Lengkap (RAL) dengan uji ragam (ANOVA) apabila data memiliki beda nyata pada taraf uji 5% (P≤ 0,5) maka dilanjutkan uji Duncan . Konsentrasi ekstrak yang diujikan yaitu 0%, 5%, 10%, 15%, 25% dan 50%. Ekstrak daun juwet mampu menghambat pertumbuhan E. coli dan S. aureus ATCC yang ditandai dengan terbentuknya zona bening. Konsentrasi ekstrak daun juwet (S. cumini) yang efektif menghambat pertumbuhan E. coli dan S. aureus ATCC adalah konsentrasi 50% dengan diameter zona hambat 18,9 mm untuk E. coli dan 16,5 mm untuk S. aureus ATCC. Skrining uji fitokimia ekstrak daun juwet positif mengandung senyawa alkaloid, fenolik, saponin dan steroid.
Kata Kunci : Ekstrak daun juwet (Syzygium cumini), Escherichia coli , Staphylococcus aureus ATCC, daya hambat
ABSTRACT
Bacterial Escherichia coli dan Staphylococcus aureus ATCCis a normal flora bacteria that naturally exist human body. This bacteria may by pathogenic if it exceeds acertain limits. To prevent the disease caused, need to be overcome by using herbal ingredients one of them is juwet leaves (Syzygiumcumini).The purpose of the study was to determine wheter the extract of juwet leaf (S. cumini) can inhibited the growth of E. coli and S. aureus ATCC and to know compounds contained in juwet leaf extract (S. cumini). This research used diffusion wells methodwith 6 treatments and 4 replications. Date analysis using completely randomized design (CRD) with using ANOVA variance analysis. If the date obtained has a real difference test level at the 5% (P≤ 0,5) that continue with Duncan test. Concentration of the extract tested was 0%, 5%, 10%, 15%, 25% and 50%. Juwet leaf extract is able to inhibited the growth of E. coli and S. aureus ATCC which is shown by the formation of clear zone. Concentration extract leaf which is effective to inhibit E. coli and S. aureus ATCC is the concentration 50% (18,9 mm) for E. coli and (16,5 mm) for S. aureus ATCC. Screening of phytochemical test of juwet leaf extract positive containing alkaloids, phenolic, steroids and saponins.
Keywords : juwet leaf extract (Syzygium cumini), Escherichia coli, Staphylococcus aureus ATCC
PENDAHULUAN
Kesehatan sangat penting dalam kehidupan manusia, jadi, untuk menjaganya harus dilakukan tindakan pencegahan dan pengobatan (Trisnayanti, 2015). Tindakan pencegahan dan pengobatan dilakukan untuk menghindari resiko terjadinya infeksi. Infeksi merupakan penyakit yang disebabkan oleh mikroorganisme pathogen dalam tubuh. Bakteri yang beresiko menyebabkan infeksi yaitu E. coli dan S. aureus ATCC. Infeksi saluran pencernaan, infeksi kulit dan diare adalah beberapa penyakit yang dapat ditimbulkan oleh bakteri E. coli dan S. aureus ATCC (Rahayu, 2013). Bakteri E. coli merupakan flora normal yang menempati saluran pencernaan (Cushine dan Lamb, 005). Bakteri S. aureus ATCC adalah flora normal yang terdapat pada kulit dan saluran pernapasan manusia.
Tumbuhan juwet (Syzygium cumini) merupakan tumbuhan yang memiliki khasiat sebagai obat tradisional. Hasil penelitian Prabhakaran et al., (2011) menunjukkan bahwa ekstrak daun juwet mengandung senyawa alkaloid, fenol, flavonoid, tannin, minyak atsiri sebagai metabolit sekunder. Selain itu, dalam penelitian tersebut dinyatakan bahwa ekstrak etanol daun juwet memiliki kemampuan antimikroba yang sangat tinggi terhadap bakteri Gram positif dan Gram negatif. Berdasarkan hal tersebut dan masih sedikitnya penelitian tentang tumbuhan juwet, maka dilakukan penelitian tentang uji daya hambat ekstrak daun juwet terhadap pertumbuhan E. coli
dan S. aureus ATCC dan uji fitokimia untuk mengetahui golongan senyawa yang terkandung pada ekstrak daun juwet.
MATERI DAN METODE
Penelitian ini dilakukan di Laboratorium Mikrobiologi Jurusan Biologi Fakultas Matematika dan Ilmu Pengetahuan Alam Universitas Udayana pada bulan Januari 2017. Penelitian ini menggunakan sampel berupa daun juwet (S. cumini) yang diambil dari bukit jimbaran. Sampel daun juwet (S. cumini) diekstrak dengan cara yaitu daun dikering anginkan, setelah kering kemudian diblender sampai terbentuk bubuk. Selanjutnya, ditimbang sebanyak 25 gram, dimasukkan ke dalam botol Erlenmeyer, kemudian ditambahkan etanol sebanyak 250 mL. Kocok hingga bubuk tercampur seluruhnya dengan etanol, selanjutnya dimaserasi selama 72 jam. Selanjutnya disaring menggunakan kertas saring, hasil filtrat yang diperoleh diencerkan dengan etanol untuk mendapatkan konsentrasi 5%, 10%, 15%, 25% dan 50%.
Pembuatan suspensi bakteri yaitu dilakukan dengan menginokulasi 1 loof jarum ose biakan murni E. coli dan S. aureus ATCC yang berasal dari stock kultur ke dalam 10 mL medium Nutrien Broth. Kemudian diinkubasi pada suhu 370C dalam waktu 24 jam sampai didapatkan kerapatan bakteri uji yang setara dengan 108 CFU. Selanjutnya uji daya hambat ekstrak daun juwet yang dilakukan dengan menggunakan metode sumur difusi (Dwijoseputro, 2008). Pertama disiapkan

DIRECTORY OF
OPEN ACCESS
JOURNALS
cawan Petri steril yang telah diisi 1 mL suspensi biakan bakteri. Dituangkan sebanyak 10 mL media Nutrien Agar (NA). Selanjutnya digoyang-goyangkan secara simultan agar bakteri dapat tumbuh merata. Kemudian, diamkan hingga media memadat, setelah media memadat lalu dibuat sumur difusi dengan diameter 5 mm. Selanjutnya masukkan ekstrak sebanyak 20 µL, lalu diinkubasi pada suhu 370C dalam waktu 24 jam. Selanjutnya ukur diameter zona bening yang terbentuk sebanyak 4x kemudian dirata-ratakan untuk mendapatkan data yang representatif.
Uji fitokimia ekstrak daun juwet (Syzygium cumini) yaitu pertama uji alkaloid yang dilakukan dengan melarutkan ekstrak ke dalam 10 mL kloroform amoniak, ditambah 0,5 mL H2SO4 kemudian dihomogenkan dan didiamkan sampai terbentuk dua lapisan, diambil bagian lapisan atas kemudian ditetesi pereaksi Meyer sebanyak 1 tetes. Apabila terbentuk endapan maka ekstrak tersebut dinyatakan postif mengandung alkaloid (Farnsworth, 2006). Kedua uji fenolik dan flavonoid yaitu dilarutkan ekstrak ke dalam etanol 70% dan dipanaskan, kemudian disaring. Hasil filtrat tersebut diletakkan pada plat tetes kemudian ditambahkan Mg dan HCl untuk identifikasi flavonoid dan ditambahkan FeCl3 untuk identifikasi fenolik. Apabila terjadi perubahan warna menjadi kemerahan maka ini menunjukkan hasil positif adanya kandungan senyawa flavonoid pada ekstrak tersebut, sedangkan hasil positif fenolik ditandai dengan terbentuknya cincin hijau sampai keunguan (Santoso et al., 2012). Ketiga uju steroid dan terpenoid yaitu sampel ekstrak daun juwet ditambahkan kloroform kemudian dipanaskan selama 10 menit, setelah panas sampel diletakkan pada plat tetes kemudian ditambahkan pereaksi Lb (asam antridat asetat + H2SO4 pekat). Apabila terjadi perubahan warna menjadi merah, pink atau violet menandakan esktrak
positif mengandung terpenoid dan apabila warnanya berubah menjadi hijau atau ungu maka sampel dinyatakan positif mengandung steroid (Santoso et al., 2012). Terakhir uji saponin yaitu ekstrak daun juwet diambil sebanyak 0,1 gram, kemudian dilarutkan dalam 5 mL aquades panas, selanjutnya dikocok kurang lebih 10 detik. Apabila terbentuk buih atau busa yang stabil kurang lebih 10 menit ini menandakan bahwa ekstrak tersebut positif mengandung senyawa saponin (Depkes RI, 2009).
Metode pengolahan data
Data yang didapat, dianalisis dengan analisis ragam (Anova) dan apabila data tersebut memiliki beda nyata pada taraf uji 5% (P≤ 0,05) maka untuk mengetahui perbedaan antar perlakuannya, analisis data akan dilanjutkan dengan uji Duncan.
HASIL
Hasil uji daya hambat ekstrak daun juwet (S. cumini) pada bakteri E. coli dan S. aureus ATCC diperoleh bahwa ekstrak tersebut mampu menghambat pertumbuhan dari bakteri E. coli dan S. aureus ATCC. Berdasarkan hasil analisis, rata-rata diameter zona hambat semua konsentrasi ekstrak yang diujikan pada E. coli diperoleh hasil yang berbeda nyata, sedangkan pada S. aureus ATCC konsentrasi 15% secara statistik tidak berbeda nyata dengan konsentrasi 10% dan 25% namun secara pengukuran diameternya diperoleh hasil yang berbeda yaitu 10% (14,6 mm), 15% (15,1 mm), dan 25% (15,4 mm). Rata-rata diameter zona hambat yang terbentuk pada konsentrasi 50% terhadap E. coli sebesar 18,9 mm ± 0,031 sedangkan pada konsentrasi yang sama terhadap S. aureus ATCC yaitu sebesar 16,5 ± 0,041, (Tabel 1) dan (Gambar 1)
Tabel 1. Rata-rata diameter zona hambat ekstrak daun juwet (Syzygium cumini) terhadap Escherichia coli dan Staphylococcus aureus ATCC

a b c
|
Konsentrasi |
N |
Rata-rata E. coli (mm) |
Rata-rata S. aureus ATCC (mm) |
|
0% |
4 |
0.00 ± 0.000a |
0.00 ± 0.000a |
|
5% |
4 |
9.00 ± 0.000b |
8.00 ± 0.000b |
|
10% |
4 |
15,6 ± 0.024c |
14,6 ± 0.048c |
|
15% |
4 |
16,0 ± 0.020d |
15,1 ± 0.025cd |
|
25% |
4 |
16,6 ± 0.025e |
15,4 ± 0.048d |
|
50% |
4 |
18,9 ± 0.031f |
16,5 ± 0.041e |
Keterangan : Nilai rata-rata yang diikuti dengan notasi huruf yang berbeda pada kolom yang berbeda menunjukkan hasil yang berbeda nyata pada taraf uji 5% (P≤ 0,05)
Gambar 1. Aktivitas antibakteri ekstrak daun juwet (Syzygium cumini) terhadap
Escherichia coli (A), Staphylococcus aureus ATCC (B), ekstrak daun juwet (a), zona bening (b), biakan bakteri (c), kontrol (k)
Hasil uji skrining fitokimia ekstrak daun juwet (S. cumini) menunjukkan bahwa ekstrak daun juwet positif mengandung senyawa diantaranya alkaloid, fenolik, saponin dan steroid. Senyawa yang paling banyak terkandung pada ekstrak daun juwet (S. cumini) adalah fenolik, saponin dan
steroid. Kandungan senyawa yang jumlahnya paling banyak pada ekstrak daun juwet yaitu fenolik, steroid dan saponin, senyawa yang jumlahnya sedang yaitu alkaliod. Namun, untuk hasil pengujian golongan senyawa flavonoid dan terpenoid menunjukkan hasil negatif, (Tabel 2 )dan (Gambar 2)
Directoryof OPEN ACCESS JOURNALS
Tabel 2. Hasil uji skrining fitokimia dari ekstrak daun juwet (Syzygium cumini)
|
Uji Fitokimia |
Pereaksi |
Hasil |
Keterangan | ||
|
1 |
2 |
3 | |||
|
Alkaloid |
Meyer |
+ |
+ |
Terbentuk endapan | |
|
Fenolik |
FeCl3 |
+ |
+ |
+ |
Berubah warna menjadi hijau |
|
Falvonoid |
Mg + HCl |
- |
- |
- |
Tidak terbentuk warna jingga |
|
Saponin |
Air + HCl |
+ |
+ |
+ |
Terbentuk busa |
|
Steroid |
LB (Liebermann-burchard) |
+ |
+ |
+ |
Terbentuk warna hijau |
|
Terpenoid |
LB (Liebermann-burchard) |
- |
- |
- |
Tidak terbentuk cincin cokelat |
Keterangan : Banyak ( + + + ) Sedikit ( + ) Sedang ( + + ) Tidak ada ( - )

Gambar 2. Hasil uji skrining fitokimia ekstrak daun juwet (Syzygium cumini) alkaloid (A), fenolik (B), saponn (C), terpenoid (D)
Pembahasan
-
1. Daya hambat ekstrak daun juwet (Syzygium cumini) terhadap pertumbuhan Escherichia coli dan Staphylococcus aureus ATCC
Berdasarkan uji yang dilakukan diperoleh hasil yaitu ekstrak daun juwet (S. cumini) mampu menghambat pertumbuhan E. coli dan S. aureus ATCC. Rata-rata diameter zona hambat untuk semua konsentrasi ekstrak yang diujikan pada E. coli diperoleh hasil yang berbeda nyata dengan kontrol pada taraf uji 5% (P ≤ 0,05). Sedangkan yang diujikan pada S. aureus ATCC secara statistik konsenrasi ekstrak 15% tidak berbeda nyata dengan konsentrasi 10% dan 25% namun secara pengukuran diperoeh hasil yang berbeda yaitu 10% (14,6 mm), 15% 15,1 mm) dan 25% (15,4 mm). Daya hambat eksrak daun juwet (S. cumini) yang diujikan pada E. coli dan S. aureus ATCC ditandai yaitu terbentuknya zona bening di daerah pingiran sumur difusi. Kekuatan antibakteri suatu ekstrak ditentukan oleh besarnya zona hambat yang terbentuk. Kekuatan antibakteri digolongkan menjadi empat kategori yaitu kategori sangat kuat, kuat, sedang dan lemah. Ekstrak dikatakan memiliki daya hambat dengan kategori sangat kuat apabila diameter daya hambat yang dihasillkan lebih dari 20 mm.Ekstrak dikatakan memiliki daya hambat dengan kategori kuat apabila diameter daya hambat yang dihasilkan berkisar antara 10 mm- 20 mm. Ekstrak dikatakan memiliki diameter daya hambat kategori sedang apabila daya hambatnya berkisar antara 5 mm - 10 mm dan diameter daya hambat suatu ekstrak dikatakan lemah yaitu apabila diameter zona hambat yang dihasilkan kurang dari 5 mm (Davis dan Stout, 1971).
Berdasarkan penggolongan kekuatan antibakteri tersebut, maka daya hambat ekstrak daun juwet (S. cumini) pada bakteri E. coli dengan konsentrasi 5% (9 mm) termasuk kategori sedang, konsentrasi 10% (16,6 mm) dan 50% (18,9 mm) termasuk kategori kuat. Sedangkan daya hambat ekstrak daun
juwet (S. cumini) pada bakteri S. aureus ATCC dengan konsentrasi ekstrak 5% (8 mm) termasuk kategori sedang, konsentrasi ekstrak 10% (14,6 mm) 15 % (15,1 mm), 25% (15,4 mm) dan 50% (16,5 mm) termasuk kategori kuat. Dengan demikiam dapat diketahui konsentrasi ekstrak yang paling besardalam menghambat bakteri E. coli dan S. aureus ATCC adalah konsentrasi 50%, sebab pada konsentrasi tersebut antibakterinya dikategorikan kuat untuk menghasilkan zona hambat paling besar Hastari, 2012).
Akivitas ekstrak daun juwet (S. cumini) dalam menghambat pertumbuhan bakteri E. coli yang termsuk bakteri Gram postiflebih peka dibandingkan dengan bakteri S. aureus ATCC yang termasuk bakteri Gram negatif, dapat dilihat perbandingannya pada (Gambar 1), hal ini disebabkan karena dinding sel kedua jenis bakteri tersebut berbeda. Lapisan peptidoglikan yang menyusun dinding sel bakteri Gram positif terdiri dari struktur yang tebal dan kaku serta mengandung substansi dinding sel yang disebut asam teikoat, sedangkan lapisan peptidoglikan yang menyusun dinding sel bakteri Gram negatiftipis sehingga dinding selnya mudah rusak. Peptidoglikan merupakan komponen yang digunakan untuk mempertahankan keutuhan sel. Karena sedikit dan tipisnya lapisan peptidogilkan serta tidak adanya kandungan asam teikoat yang menyusun dinding sel bakteri Gram negatif bakteri Gram negatif menyebabkan dinding selnya lebih rentan mengalami kerusakan ketika diberikan antibakteri (Radji, 2011).
Kemampuan suatu ekstrak dalam menghambat pertumbuhan mikroba tergantung konsentrasi dari ekstrak tersebut (Schlegel, 1994). Berdasarkan hasil uji pada (Tabel 1), menunjukkan diameter zona hambat pertumbuhan E. coli dan S. aureus ATCC pada konsentrasi ekstrak 50% lebih besar dibandingkan dengan konsentrasi ekstrak 5%, 10%, 15% dan 25%. Hal ini membuktikan bahwapemberian konsentrasi ekstrak yang semakin tinggi akan menimbulkan zona hambat yang semakin besar (Lingga dan Rustama, 2005). Selain pengaruh konsentarsi, kemampuan suatu ektrak dalam
Directoryof OPEN ACCESS JOURNALS
menghambat pertumbuhan bakteri juga ditentukan oleh golongan senyawa antimikroba yang dihasilkan oleh ekstrak tersebut (Ajizah, 2004). Dalam penelitian ini aktivitas antimikroba daun juwet (S. cumini) disebabkan karena adanya kandungan senyawa metabolit sekunder yaitu akaloid, fenolik, steroid dan saponin.
Mekanisme penghambatan bakteri oleh senyawa antibakteri yang terkandung pada ekstrak daun juwet (S. cumini) yaitu dengan merusak dinding sel sehingga mengakibatkan lisis. Kemudian terjadi perubahan permeabilitas membran sitoplasma yang menyebabkan kebocoran nutrien dari dalam sel, mendenaturasi protein serta penghambatatan kerja enzim intraselulersehingga terjadi kerusakan sistem metabolisme didalam sel (Poeloengan et al., 2006).
-
2. Skrining Fitokimia Ekstrak Daun Juwet (Syzygium cumini)
Analisis golongan senyawa ektrak daun juwet (S. cumini) dilakukan dengan tes uji warna menggunakan beberapa pereaksi. Hasil uji diperoleh bahwa ekstrak daun juwet (S. cumini) positif mengandung senyawa diantaranya alkaloid, fenolik, saponin dan steroid. Penelitian sebelumnya yang dilakukan oleh (Taher, 2011), juga menyebutkan bahwa ekstrak daun juwet (S. cumini) mengandung senyawa alkaloid, flavonoid, minyak atsiri, terpenoid, steroid, fenoik dan saponin. Namun dalam penelitian ini, untuk senyawa flavonoid belum teridentifikasi hal ini kemungkinan dikarenakan pemilihan metode yang digunakan untuk mengidenifikasi senyawa flavonoid dalam peneitian ini kurang tepat. Adapun metode yang digunakan untuk mengidentifikasi senyawa flavonoid dalam penelitian ini yaitu dengan uji Wilstatter. Sebenarnya selain uji Wilstatter senyawa flavonoid juga dapat diidentifikasi dengan metode lain yaitu uji Bate- Smith dan uji dengan NaOH 10% (Harbone, 1987). Selain itu penyebab tidak teridentifikasinya senyawa favonoid dan terpenoid kemungkinan juga dikarenakan adanya pengaruh faktor lingkungan yang mempengaruhi pembentukan metabolit sekunder pada tumbuhan yaitu ketinggian tempat tumbuh, pH tanah, kelembaban udara dan intensitas cahaya matahari (Creswel et al., 2005).
Mekanisme kerja alkaoid yang terkandung pada ekstrak daun juwet ( S. cumini) sebagai antibakteri yaitu komponen peptidoglikan penyusun sel bakteridiganggu yang mengakibatkan terjadinya lisis pada lapisan dinding sel bakteri (Septiana, 2011). Mekanisme kerja saponin sebagai antibakteri yaitu dengan mendanaturasi protein. Karena zat aktif permukaan saponin mirip deterjen maka saponin dapat digunakan sebagai antibakteri dimana tegangan permukaan dinding sel bakteri akan diturunkan dan permeabilitas membran bakteri dirusak (Sani, 2013). Kelangsungan hidup bakteri akan terganggu akibat rusaknya membran sel. Kemudian saponin akan berdifusi melalui membran sitoplasma sehingga kestabilan membran akan terganggu yang menyebabkan sitoplasma mengalami kebocoran dan keluar dari sel yang mengakibatkan kematian sel (Pleczar dan Reid, 1972).
Mekanisme kerja fenol yaitu dengan cara meningkatkan permeabilitas membran sitoplasma sehingga menyebabkan kebocoran komponen intraseluler dan koagulasi sitoplasma sehingga terjadi lisis sel (Sufiriyanto, 2005). Senyawa fenol merupakan antibakteri yang bersifat bakterisidal. Senyawa fenol memiliki aktivitas antimikroba berspektrum luas terhadap bakteri Gram posituf dan Gram negatif sehingga senyawa fenol secara intensif dapat digunakan sebagai desinfektan (Oliver et al., 2001).
Mekanisme kerja steroid sebagai antibakteri yaitu denganmerusak membran lipid, sehingga liposommengalami kebocoran (Madduluri et al., 2013). Steroid juga diketahui dapat berinteraksi dengan membran fosfolipid,karena sifatnya yang permeabel terhadap senyawa-senyawa lipofilik menyebabkan integritas membran menurun dan morfologi membran sel terganggu yang mengakibatkan sel mengalami lisis dan rapuh(Ahmed, 2007).
SIMPULAN
Berdasarkan hasil pembahasan, maka dapat disimpulkan yaitu ekstrak daun juwet (S. cumini) mampu menghambat pertumbuhan E. coli dan S. aureus ATCC. Konsentrasi ekstrak daun juwet (S. cumini) yang efektif dalam menghambat pertumbuhan E. coli dan S. aureus ATCC adalah konsentrasi 50% dengan diameter 18,9 mm untuk E. coli dan 16,5 mm untuk S. aureus ATCC. Senyawa yang terkandung pada ekstrak daun juwet (S. cumini) yaitu alkaloid, fenolik, saponin dan steroid.
DAFTAR PUSTAKA
Ahmed, Bahar. 2007. Chemistry Of Natural Products. New Delhi: Departemen of Pharmaceutical Chemistry of Science. Jamia Hamdard.
Ajizah aulia (2004). Sensiivitas Salmonella Typhimurium Terhadap Ekstrak Daun Jambu Biji Psidium Guajava. Bioscientiae. Banjarmasin
Cushie, T. P dan Lamb, A. J. 2005. Animicrobial activity of flavonoids. Internationa Journal Of Animicrobial Agents. 26(343-356).
Creswell, C. J. Kosasih, P. & Iwang, S. 2005. Analisi Spektrum senyawa Organik. Cetakan ke-10 Edisi ketiga. Bandung: Penerbit ITB Hal : 1-10
Davis, W. W and Stout T. R. 1971. Disc Plate Method of Microbiological Antibiotic assay. Applied Microbiology. 659-665
Dwijoseputro, D. 2008. Dasar-Dasar Mikrobiologi. Jakarta : Djambatan. Hal. 6
Depkes RI. 2009. Materi Medika Indonesia. Jilid VI. Jakarta : Departemen Kesehatan Indonseisa. Hal 549-553.
Farnsworth, N. R. 2006. Biological and Phytochemical Screening of Plants. J. Pharm. Sci. Hal. 55
Hastari, R. 2012. Uji Aktivitas antimikroba ekstrak Pelepah dan Batang Tanaman Pisang Ambon (Musa paradisiaca var. Sapientum) terjadap Pertumbuhan Bakteri Staphylococcus aureus. FKU UNDIP [Karya Tulis Ilmiah}: Semarang.
Harbone, J. B., 1987. Metode Fitokimia. Penerbit ITB : Bandung.
Lingga, M. A. dan M. M., Rustama. 2005. Uji Aktivitas Antimikroba dari Ekstrak Air dan Etanol Bawang Putih (Allium sativum) terhadap Bakteri Gram Positif dan Gram Negatif yang Diisolasi dari Udang Dogol
ΓΛΓ> Λ I Directoryof
OPEN ACCESS
L√kJΛΛ⅛J JOURNALS
(Metapenaeus monoceros), Biologi FMIPA
Universitas Pajajaran : Bandung.
Madduliri, Suresh, Rao, K. Babu. Sitaram, B. 2013. In vitro evaluation of five Indegenous plants extract Againts five bacterial Phatogens of Human. International Journal of Pharmacy and Phrmaceutical Science 5(4) : 679-684.
Oliver, S. P., b. E. Gillespie, M. J. Lewis, S. J. lvey, R. A. Almeida, D. A. Luther, D. L. Johnson, K, C. Lamar, H. D. Moorehead H. H. Doelen. 2001. Efficacy of a new premikilking teat desifectant containing a phenolic combination for the frevention of mastitis. J. Dairy Sci 84 : 1545-1549.
Prabhakaran, Shylaja. 2011. Phytochemical and antimicrobial properties of Syzygium cumini and ethanomedicinal plant of Javadhu hills. Research In Pharmacy 1(1):22-32.
Poeloengan, M., Chairul, I. Komala, S. Salmah dan M. N. Susan. 2006. Aktivitas antibakteri dan fitokimia dari beberapa jenis tanaman obat. Prosiding Seminar Nasional Teknologi Peternakan dan Veteriner. Bogor. Hal. 300-305
Rahayu, I. D. 2013. Aktivitas Antibakteri Saponin Hasil Isolasi Aloe barbadensis Militer terhadap Staphylococcus aureus Penyebab Masitis pada Sapi Perah. Jurusan Peternakan Fakultas Peternakan dan Perikanan. Universitas UMM Malang (Skripsi).Tidak
dipublikasikan.
Radji, M. 2011. Mikrbiologi. Buku Kedokteran. ECG : Jakarta
Schlegel Hans g., 1994. Mikrobiologi Umum. Penterjemah Tedjo Baskoro. Edisi keenam Gajah Mada University Press: Yogyakarta
Sufiriyanto Indraji, M. 2005. Aktivitas Pemberian Ekstrak Temulawak (Curumae xanthoriza ) dan Kunyit (Curcumae domestica) terhadap Escherichia coli dan Staphylococcus. Jurnal Biologi. 11(15-23)
Sani, R. N., Nisa, F. C., Andriani, R. D., dan Madigan, J. M . 2013. Analisis reedmen dan skrining fitokimia ekstrak etanol mikroalga laut (Tetraselmis chui ). Jurnal Pangan dan Agroindustri. 2 (2): 121-126
Santoso, J., S. Anwariah. R. O. Rumiantin, A. P. Putri, N. Ukhty and Y. Yoshie-Stark. 2012. Phenol Conten. Antioxidan Activity and Fibers profile of Four Tropical Seagrasses From Indonesia. Journal Of Medical Plants, 10 (37): 73-79
Trisnayanti, K.A. 2015. Daya hambat Ekstrak Temu Putri (Curcuma petiole Roxb) pada beberapa bakteri Gram negatif. Jurusan Biologi Fakultas MIPA Universitas Udayana. (Skripsi). Tidak dipublikasikan
Taher, Tamrin. 2011. Identifikasi Senyawa Flavonoid dari Estrak Metanol Kulit Batang Langsat (Lansium domesticum L). Skripsi. UNG
51
Discussion and feedback